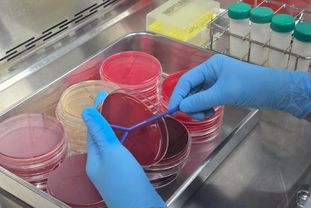

전국신문언론노동조합 김성길 기자 | 전라남도는 5일 도청 왕인실에서 2025년 정책자문위원회 전체회의를 열어 도정 성과와 새 정부 국정과제에 반영된 전남의 주요 정책을 공유하고 당면 과제를 집중 논의하는 등 미래 전략 재정비에 나섰다.
이날 회의는 김영록 전남도지사, 정책자문위원회 박민서 위원장과 임영규·권욱 부위원장 등 200여 명이 참석한 가운데 1부 전체회의와 2부 분과별 회의로 나눠 진행됐다.
1부 전체회의에선 도정 성과와 운영방향을 논의하고, 신규 정책자문위원을 위촉했다.
오픈 AI와 SK의 AI 데이터센터 투자, 삼성SDS 컨소시엄의 국가 AI컴퓨팅센터 입지 선정, 인공태양 연구시설 부지로 나주시 1순위 선정, 국고 예산 10조 원 달성 등 굵직한 성과와 함께 전남이 AI·에너지 수도로 자리매김할 비전을 제시했다.
김영록 지사는 “지난해 불법 비상계엄 이후, 케이(K)-민주주의를 회복하고 전남이 굵직한 성과를 거둔 것은 모두 정책자문위원 덕분”이라며 “최근 전남은 AI 데이터센터, 컴퓨팅센터, 인공태양 연구시설 유치, 누리호 발사와 국산화 등 첨단 산업도시로 우뚝 서 천지개벽을 이뤄냈다”고 강조했다.
이어 “여수 석유화학, 광양 제철 등 지역에 어려움도 있지만 몇 년 전 어려웠던 조선사업의 부활을 이뤄낸 것처럼 고부가가치화, 친환경화, 구조조정, 정부의 고용위기 선제대응지역 지정 등을 바탕으로 위기를 잘 극복하고 경쟁력을 확보할 것으로 기대한다”고 덧붙였다.
또한 “앞으로 전남도가 첨단산업, 농수산, 문화 관광 등 다양한 분야에서 ‘전남시대’를 열도록 자문위원회의 성원과 조언을 당부한다”고 말했다.
2023년부터 정책자문위원회를 이끈 박민서 위원장은 “최근 전남이 거둔 굵직한 성과를 바탕으로 ‘남악 500년 시대’가 열릴 것”이라며 “정책자문위가 도정을 적극 뒷받침하도록 제언과 지지를 아끼지 않겠다”고 밝혔다.
2부 행사는 신재생에너지, 전략산업, 관광, 문화, 농업, 수산, 여성 등 14개 분과별 회의로 나눠 각각 진행됐다.
분과별로 가장 화두인 전남형 기본소득을 비롯해 RE100 산단 유치, 전남 섬 방문의 해 운영, 그린바이오 육성, 목포~보성선 활성화 방안 등이 주로 논의됐다.
특히 성과에 대한 논의보다 ▲석유화학·철강·조선 등 주력산업 침체 ▲청년인구 유출 등 지방소멸 ▲외국인 관광객 유입 등 전남이 상대적으로 부족한 현안을 깊게 논의하고 의견을 나눴다.
분과별 위원들은 자신이 가진 전문성을 바탕으로 가감없이 의견을 내고, 현장의 목소리를 전했다.
전남도는 회의에서 제시된 제안을 모아 ‘지금은 전남 시대’를 열어가는 데 밑거름으로 삼을 예정이다.
지난 2004년 시작된 전남도 정책자문위원회는 14개 분야, 전문가 324명으로 구성됐다. 올해 ▲국가 지질공원 인증 ▲섬진강 국가정원 조성 ▲목재 펠릿 활용 다양화 ▲공공어린이 재활의료센터 운영 ▲노숙인 자립 지원 등 행정을 앞서가는 정책을 제안했다.
전남도는 앞으로 정책자문위원회가 흔들림 없이 정책을 제언하고 자문위원이 역량을 펼치도록 다양한 자리를 마련하는 등 꾸준히 소통할 계획이다.